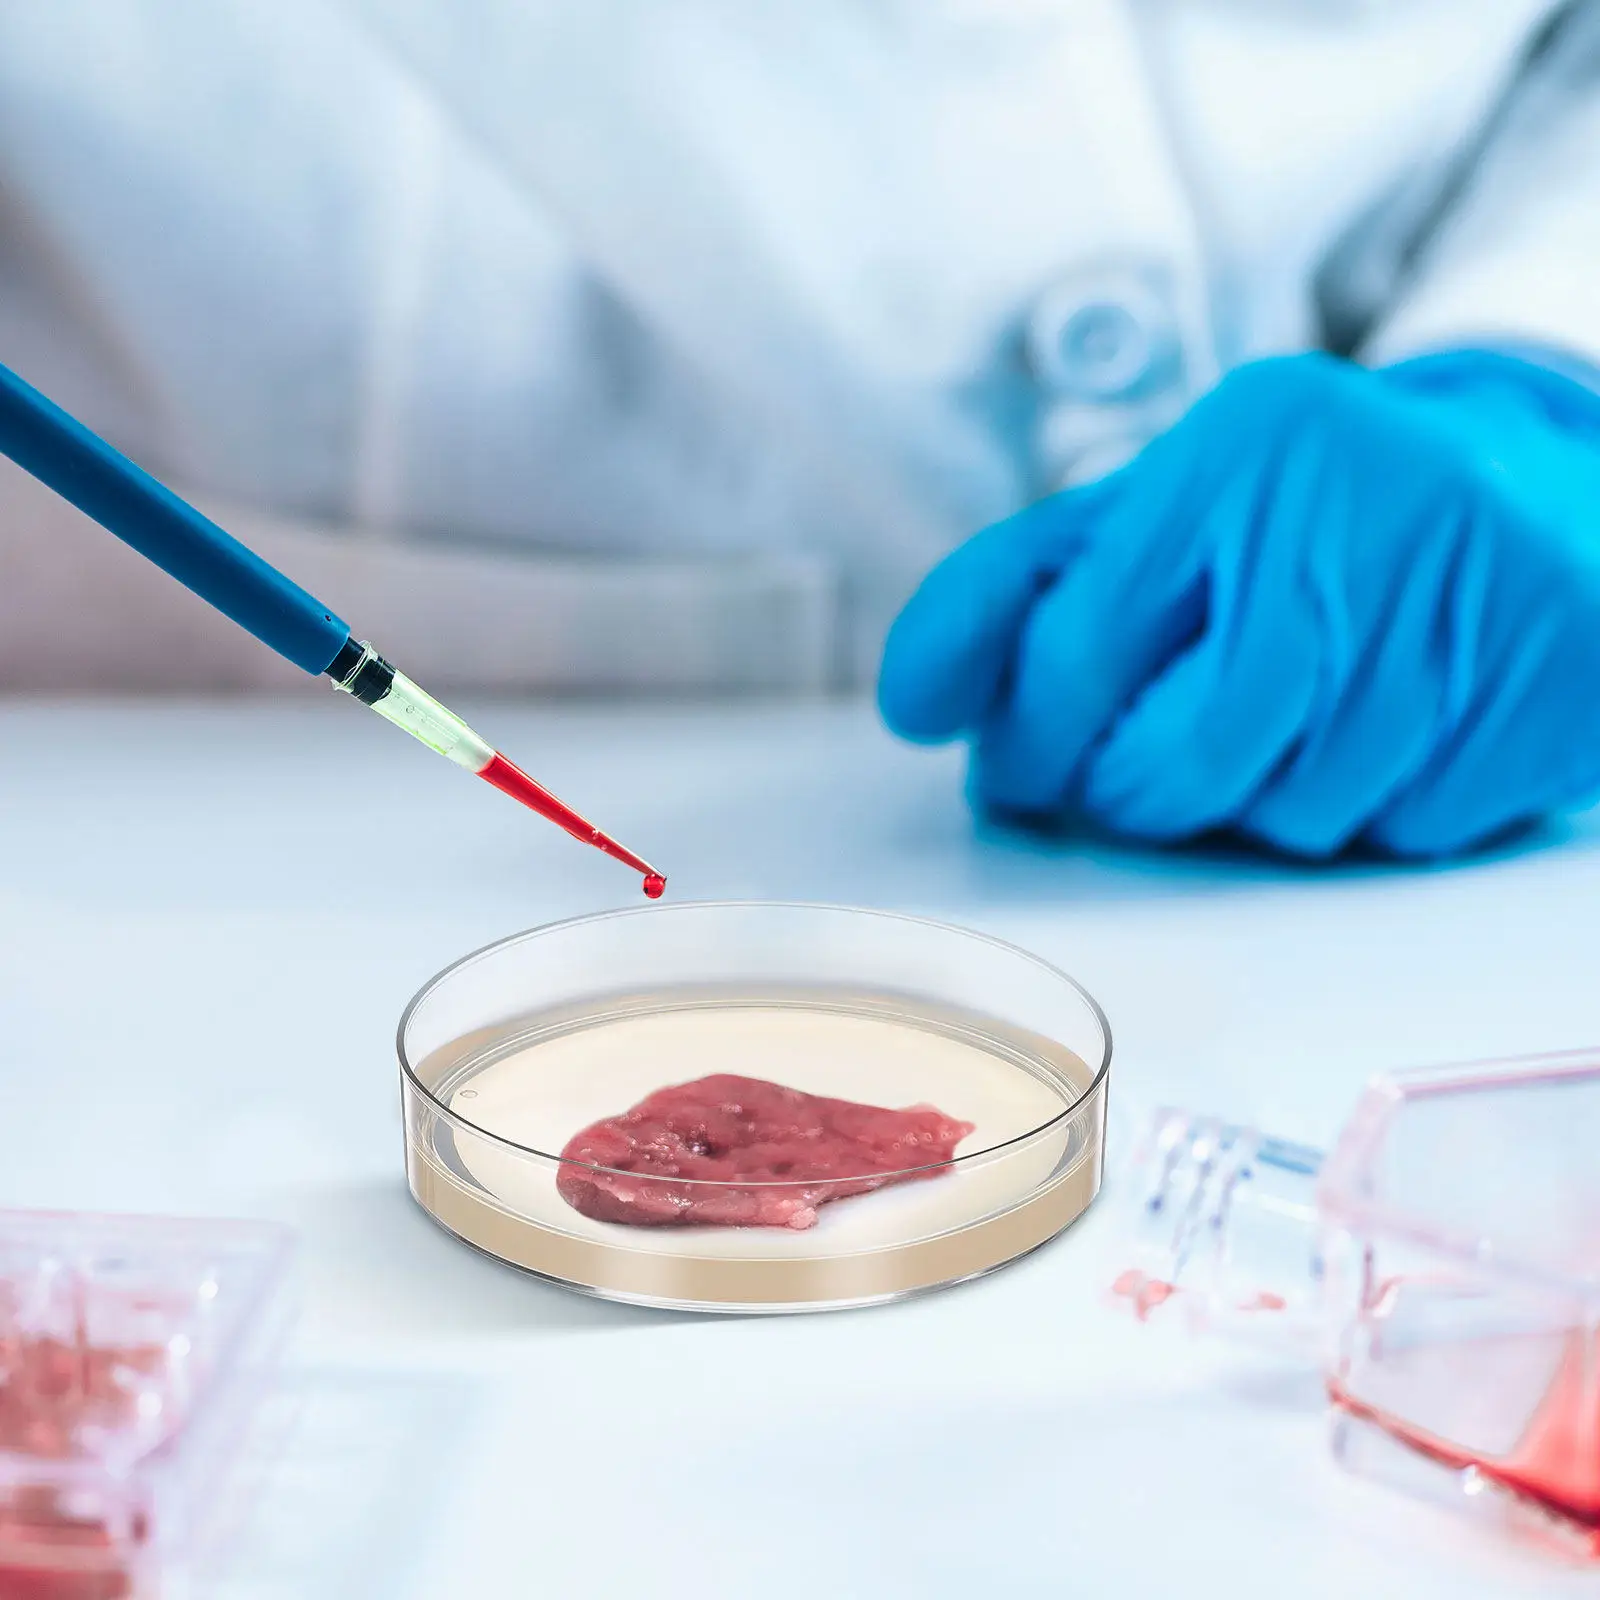
10pcs Nutrient Agar Plates 7Cm Prepoured Petri Dishes Thick Agar Layer For Stem Science Experiments Laboratory Supplies

Round Chalkboard Social Media Icons


Em & Dash
sku: 646137
ACCORDING TO OUR RECORDS THIS PRODUCT IS NOT AVAILABLE NOW
$8.00
Shipping from: United States
Description
The Chalkboard Buttons/Icons are the perfect addition to any blog or website. - - - - - - - - - - - - - - - - - - - - - - - - - - - - - - - - - - - - - - - - - - - - - - - - - - - - - - - - Download Includes: - 11 Social Media Icons 1 Blank Icon - 3 sizes: 64px, 48px, 32px - 3 styles: Outline, Clean, and Dusty - .zip file of icons in transparent .png format - Layered Photoshop file to customize in Photoshop of Photoshop Elements Made with Photoshop CC
Technical Details
| _GoogleCategoryID: | 5034 |
Price history chart & currency exchange rate
Customers also viewed

$20.68
Фильтр качества воздуха HEPA-канальный фильтр Композитный фильтр с активированным углем Эффективная система фильтрации Эффективный воздушный фильтр в помещении
aliexpress.ru
$1.65
Bamboo Coaster Tray 4 Holes Glass Holder Anti Slip Elegant Bars KTV Flight Tasting Beer Bottle
aliexpress.ru
$11.08
2pcs Durability Titaniums Carabiner Light weight Carabiner Keychains Adventure Dropship
aliexpress.com
$85.86
Автомобильный комплект для обновления лампы головного света, запасные части для Land Rover Defender 90-16 90/110 83-90
aliexpress.ru
$32.88
Ручной Мини-счетчик частоты GY561, измеритель мощности для двусторонней радиосвязи
aliexpress.ru
$1.77
Подставка для мяча из АБС-пластика, подставка для игрушек, держатель для дисплея, опорная основа для футбола, мяча для регби,
aliexpress.ru
$3.43
Hazelnut Walnut Pliers Quick Chestnut Gadgets Nut Cracker Clip Sheller Opener Cutter Clamp Plier Portable Kitchen Accessories
aliexpress.com
$4.87
Watercolor Flower sticker fence Bird self-Adhesive painting warm and romantic bedroom background wall door wall sticke
aliexpress.com
$7.44
6pcs 80/120 Grit Sanding Paper Sleeve Kit Alumina Sanding Paper Drum Polishing Wheels For Polishing Metal Wood Jade Plastics
aliexpress.com
$3.52
2021 New New tie-dye grinding wool milk silk fabric braided cap short braid hair turban spot to hide
aliexpress.com
$18.04
Summer Loose O-Neck Top Wide Leg Pants Two Piece New Elegant Pullover Pants Summer Suit Women Harajuku Style Cotton Linen Suit
aliexpress.com
$12.73
Replacement Parts Accessories Kit For Ecovacs DEEBOT N79 N79S DN622 500 N79W, Yeedi K600 K700 Robotic Vacuum Cleaner
aliexpress.com
$19.95
8mm Natural Blue Light Labradorite Bracelet Jewelry For Women Men Wealth Gift Crytsal Energy Beads Moonstone Stone Strands AAAAA
aliexpress.com
$35.76
Women Hooded Muslim Hijab Dress Eid Prayer Garment Robe Abaya Long Khimar Full Cover Ramadan Gown Abayas Dress Islamic Clothes
aliexpress.com
$32.84
Original 331FLR 4-port Gigabit Network Adapter Card 629135-B21 629133-001 634025-001 for Server Adapter Card Controller Card
aliexpress.com
$40.03
2022 38000mAh 21.6V 38Ah Li-ion Battery for Dyson V6 DC58 DC59 DC61 DC62 DC74 SV09 SV07 SV03 965874-02 Vacuum Cleaner Battery
aliexpress.com
$22.70
3D VR Headset Smart Virtual Reality Glasses Headset For Smartphones Phone Lenses With Controllers Headphones 7 Inches Binoculars
aliexpress.com
$234.71
Наушники Razer BlackShark V2 Pro 2023 White RZ04-04530200-R3M1, BlackShark V2 Pro 2023
pleer.ru
$422.00
Household Smokeless robot cooking pot smart cooking Automatic meat vegetable cooker machine Food Cooking Machine BZ01
aliexpress.com
$17.50
Жакет женский Corsar на одну пуговицу размеры 42-52 разные расцветки 50, Бежевый, Бирюзовый
prom.ua
$30.98
Straight Numbering Machine 7 Digits Backward Gothie Prefix Spring Return Arm Sinkable Numbering Machine
aliexpress.com
$27.53
5pcs Dental Probe Periodontal Explorer CPI Tool 1PC Stainless Steel for Dentist Oral Hygiene Teeth Cleaning Examination Hook
aliexpress.com
$6.12
New Metal Rocker Arm High-temperature Spray Gun Lighter Windproof Inflatable Rotatable Outdoor Portable Igniter Men's Small Tool
aliexpress.com
$41.39
В наличии Kingrinder P0 Series Ручная мельница для кофейных зерен Итальянская прецизионная ручная мельница для кофе Портативная уличная домашняя кофемолка
aliexpress.ru
$2,690.69
【2025】Paktechz Carbon Fiber Body Kit For Lamborghini Huracan 580 610 EVO Front Rear Bumper & Hood With Lip For Fender Spoiler D
aliexpress.com
$13.62
New BLOKEES Original Zootopia 2 Daadoos Mini Blind Box Creative Personalized Exquisite Figures Toys Model Kids Holiday Gifts
aliexpress.com
$266.39
Steam electric iron, hanging bottle type clothes store household high-power electric heating iron
aliexpress.ru
$511.77
35HP Diesel Crawler Utility Tractor EPA CE Certified Multifunctional For Farm Plowing Digging Pushing
aliexpress.com
$21.05
10pcs Nutrient Agar Plates 7Cm Prepoured Petri Dishes Thick Agar Layer For Stem Science Experiments Laboratory Supplies
aliexpress.com
















